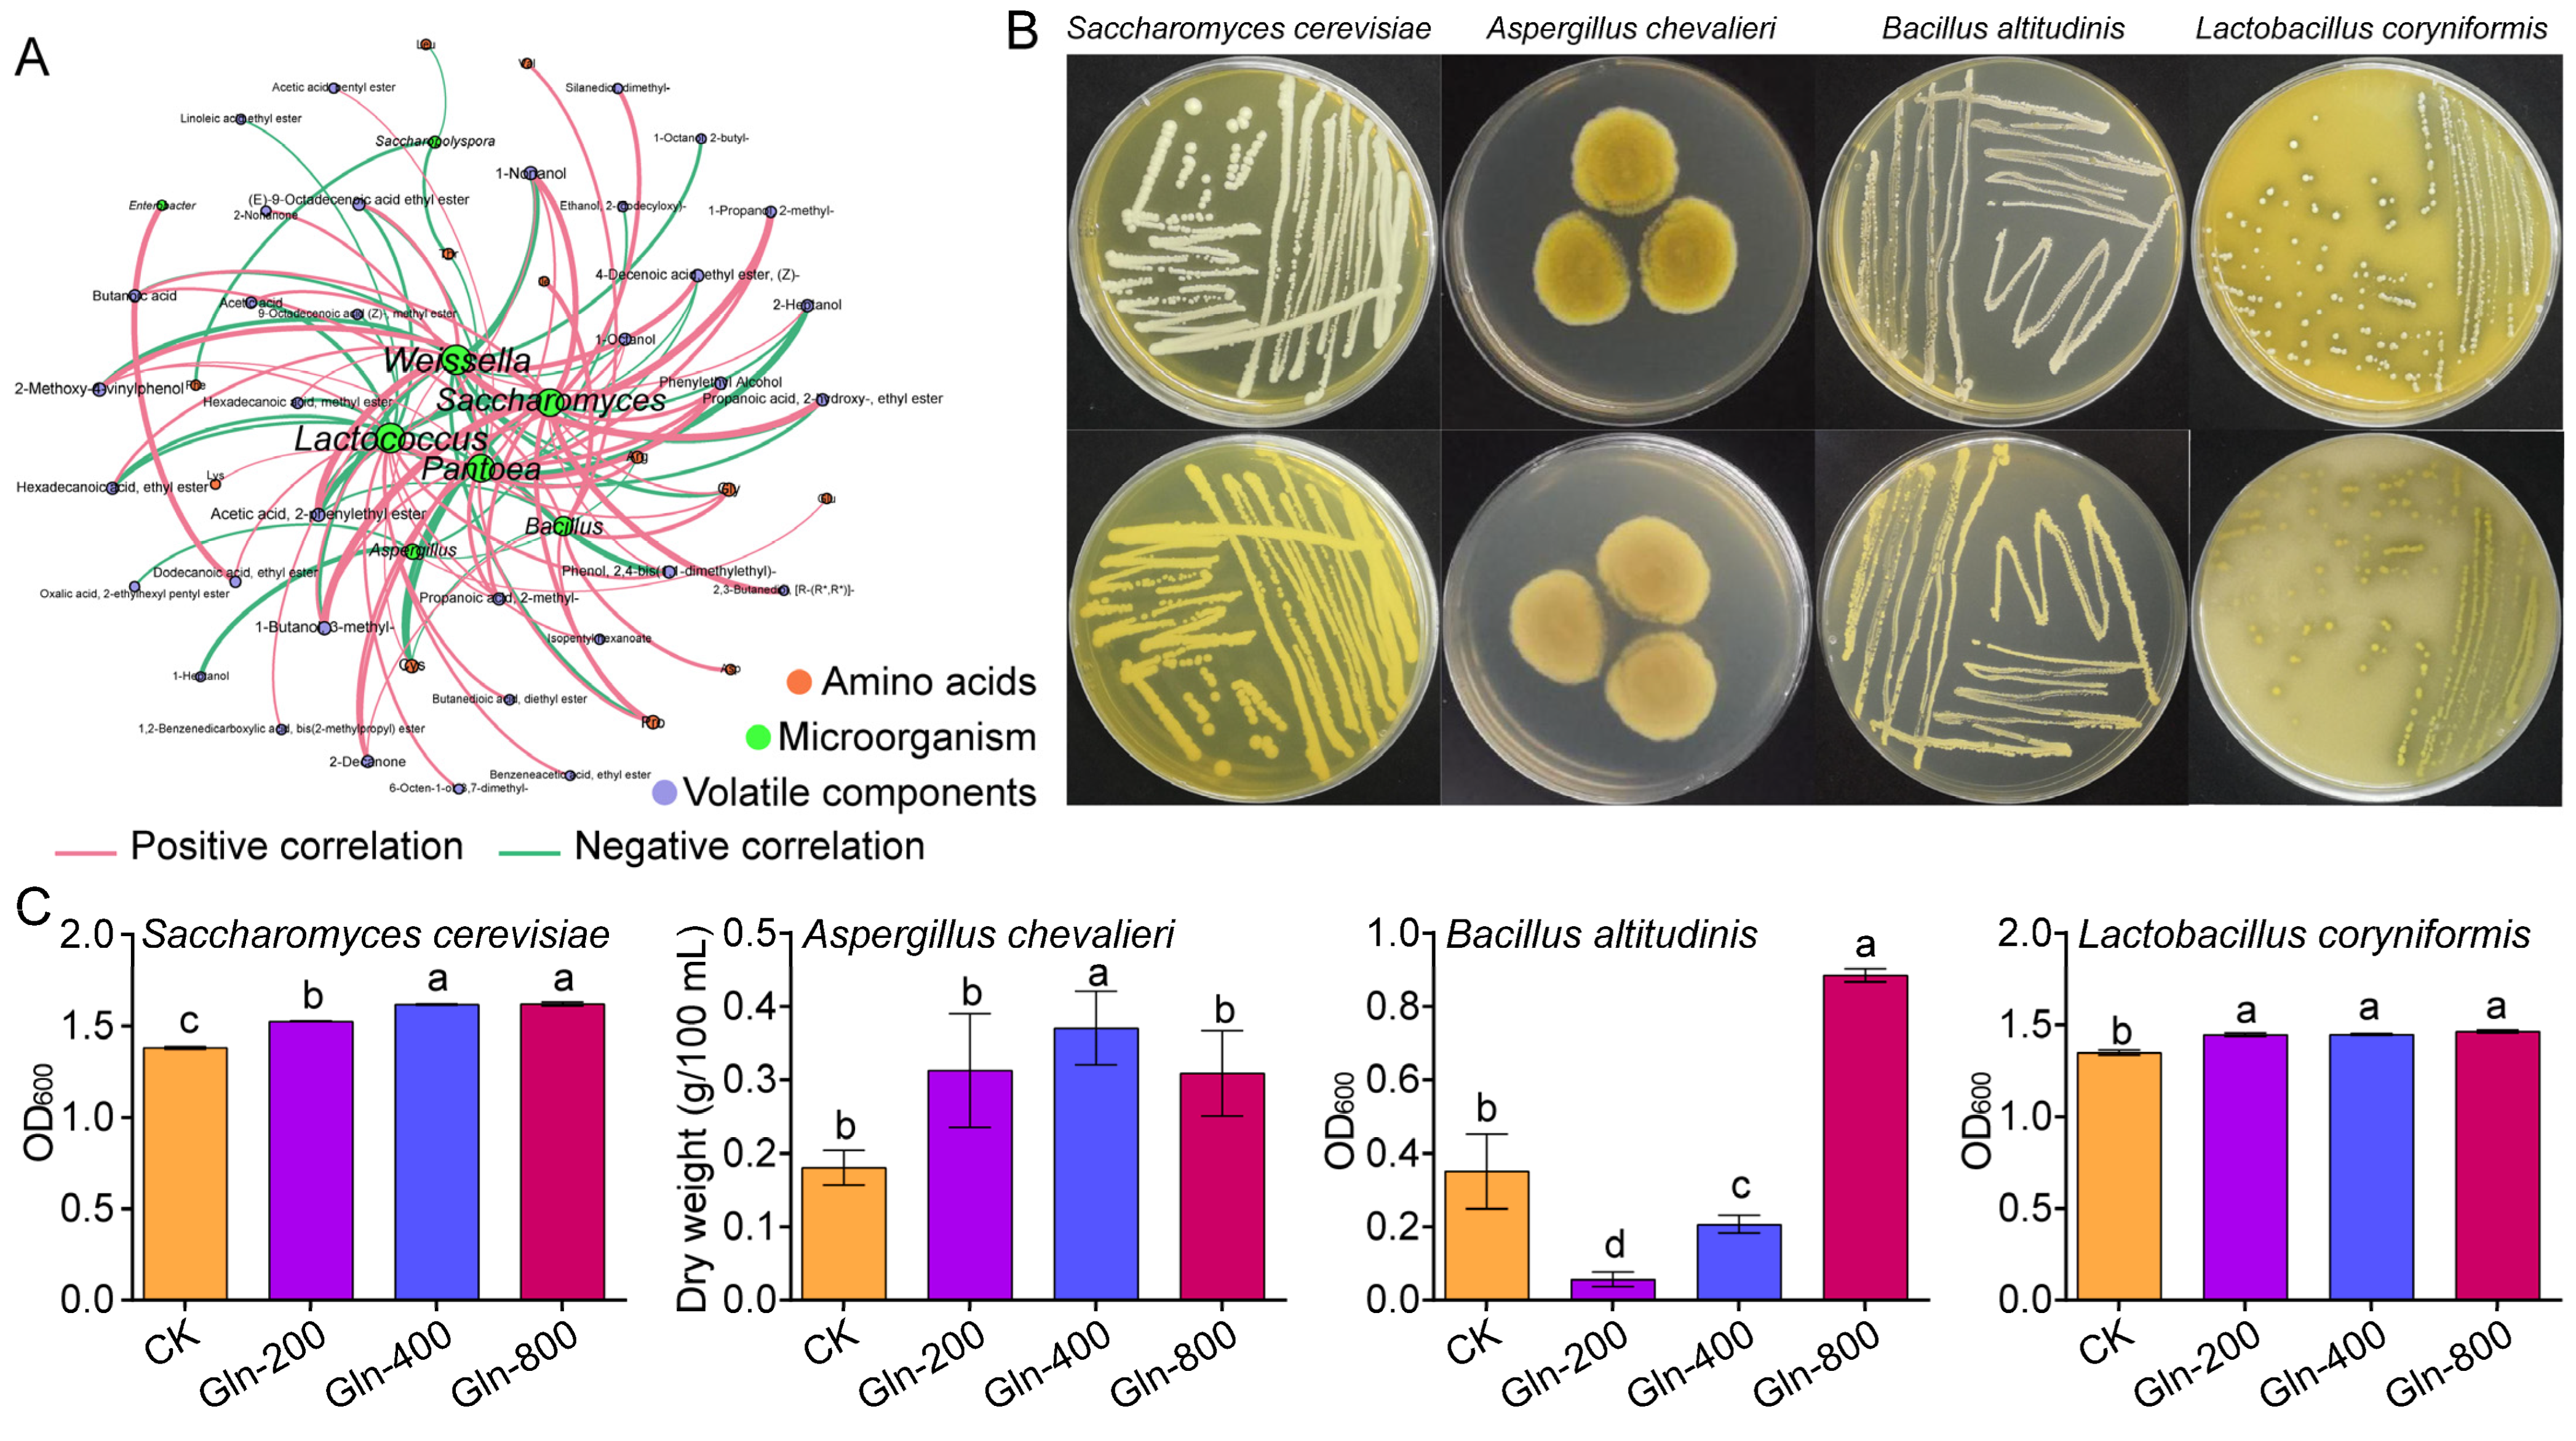
Foods 13 02833 g005

The Addition of Glutamine Enhances the Quality of Huangjiu by Modifying the Assembly and Metabolic Activities of Microorganisms during the Fermentation Process
Abstract
1. Introduction
2. Materials and Methods
2.1. Sample Preparation and Collection
2.2. Physicochemical Parameters, Flavor Substances, Free Amino Acid Detection
2.3. DAN Extraction, PCR, and Amplicon Sequencing Analysis
2.4. Microbial Isolation and Fermentation Experiment
2.5. Statistical Analysis
3. Results and Discussion
3.1. Effect of Amino Acid Addition on Physicochemical Properties of Huangjiu
3.2. Effect of Amino Acid Addition on Content of Volatile Components of Huangjiu
3.3. Effect of Gln Addition on Physicochemical Properties of Huangjiu
3.4. Analysis of Microbial Community Structure
3.5. Analysis of the Microbial Community Assembly Process
3.6. Correlation Analysis between Microorganisms and Flavor Substances
3.7. Experimental Verification of the Effect of Gln Addition on the Flavor of Huangjiu
4. Conclusions
Supplementary Materials
Author Contributions
Funding
Data Availability Statement
Acknowledgments
Conflicts of Interest
References
- Peng, Q.; Zheng, H.; Li, S.; Meng, K.; Yu, H.; Zhang, Y.; Yang, X.; Li, L.; Xu, Z.; Xie, G.; et al. Analysis on driving factors of microbial community succession in Jiuyao of Shaoxing Huangjiu (Chinese yellow rice wine). Food Res. Int. 2023, 172, 113144. [Google Scholar] [CrossRef]
- Wei, J.; Lu, J.; Nie, Y.; Li, C.; Du, H.; Xu, Y. Amino Acids Drive the Deterministic Assembly Process of Fungal Community and Affect the Flavor Metabolites in Baijiu Fermentation. Microbiol. Spectr. 2023, 11, e02640-22. [Google Scholar] [CrossRef]
- Liu, S.; Ma, D.; Li, Z.; Sun, H.; Mao, J.; Shi, Y.; Han, X.; Zhou, Z.; Mao, J. Assimilable nitrogen reduces the higher alcohols content of huangjiu. Food Control 2021, 121, 107660. [Google Scholar] [CrossRef]
- Rollero, S.; Bloem, A.; Brand, J.; Ortiz-Julien, A.; Camarasa, C.; Divol, B. Nitrogen metabolism in three non-conventional wine yeast species: A tool to modulate wine aroma profiles. Food Microbiol. 2021, 94, 103650. [Google Scholar] [CrossRef]
- Liang, Z.; Lin, X.; He, Z.; Su, H.; Li, W.; Ren, X. Amino acid and microbial community dynamics during the fermentation of Hong Qu glutinous rice wine. Food Microbiol. 2020, 90, 103467. [Google Scholar] [CrossRef]
- Takagi, H. Metabolic regulatory mechanisms and physiological roles of functional amino acids and their applications in yeast. Biosci. Biotechnol. Biochem. 2019, 83, 1449–1462. [Google Scholar] [CrossRef]
- Wang, H.; Sun, C.; Yang, S.; Ruan, Y.; Lyu, L.; Guo, X.; Wu, X.; Chen, Y. Exploring the impact of initial moisture content on microbial community and flavor generation in Xiaoqu baijiu fermentation. Food Chem. X 2023, 20, 100981. [Google Scholar] [CrossRef]
- Kessi-Pérez, E.I.; Molinet, J.; Martínez, C. Disentangling the genetic bases of Saccharomyces cerevisiae nitrogen consumption and adaptation to low nitrogen environments in wine fermentation. Biol. Res. 2020, 53, 2. [Google Scholar] [CrossRef]
- Sun, M.; Li, M.; Zhou, Y.; Liu, J.; Shi, W.; Wu, X.; Xie, B.; Deng, Y.; Gao, Z. Nitrogen deposition enhances the deterministic process of the prokaryotic community and increases the complexity of the microbial co-network in coastal wetlands. Sci. Total Environ. 2023, 856, 158939. [Google Scholar] [CrossRef]
- Chen, T.; Wu, F.; Guo, J.; Ye, M.; Hu, H.; Guo, J.; Liu, X. Effects of glutinous rice protein components on the volatile substances and sensory properties of Chinese rice wine. J. Sci. Food Agric. 2020, 100, 3297–3307. [Google Scholar] [CrossRef]
- Hofman-Bang, J. Nitrogen catabolite repression in Saccharomyces cerevisiae. Mol. Biotechnol. 1999, 12, 35–71. [Google Scholar] [CrossRef]
- Zhao, X.; Zou, H.; Fu, J.; Chen, J.; Zhou, J.; Du, G. Nitrogen regulation involved in the accumulation of urea in Saccharomyces cerevisiae. Yeast 2013, 30, 437–447. [Google Scholar] [CrossRef]
- Zhou, Z.; Yuan, Y.; Wang, K.; Wang, H.; Huang, J.; Yu, H.; Cui, X. Rootstock-scion interactions affect fruit flavor in grafted tomato. Hortic. Plant J. 2022, 8, 499–510. [Google Scholar] [CrossRef]
- Hao, J.; Tian, X.; Wu, F.; Hu, H.; Zhou, G.; Liu, X.; Zhang, T. Proteomics analysis reveals the mechanism associated with changes in fatty acids and volatile compounds of brown rice infested by Sitophilus oryzae Motschulsky. J. Stored Prod. Res. 2022, 95, 101915. [Google Scholar] [CrossRef]
- Bastian, M.; Heymann, S.; Jacomy, M. Gephi: An Open Source Software for Exploring and Manipulating Networks. In Proceedings of the Third International AAAI Conference on Weblogs and Social Media, San Jose, CA, USA, 17–20 May 2009. [Google Scholar]
- Liu, C.; Cui, Y.; Li, X.; Yao, M. microeco: An R package for data mining in microbial community ecology. FEMS Microbiol. Ecol. 2020, 97, fiaa255. [Google Scholar] [CrossRef]
- Wang, J.; Zhang, B.; Wu, Q.; Jiang, X.; Liu, H.; Wang, C.; Huang, M.; Wu, J.; Zhang, J.; Yu, Y. Sensomics-assisted flavor decoding of coarse cereal Huangjiu. Food Chem. 2022, 381, 132296. [Google Scholar] [CrossRef]
- Chen, G.-M.; Huang, Z.-R.; Wu, L.; Wu, Q.; Guo, W.-L.; Zhao, W.-H.; Liu, B.; Zhang, W.; Rao, P.-F.; Lv, X.-C.; et al. Microbial diversity and flavor of Chinese rice wine (Huangjiu): An overview of current research and future prospects. Curr. Opin. Food Sci. 2021, 42, 37–50. [Google Scholar] [CrossRef]
- Yu, H.; Guo, W.; Xie, T.; Ai, L.; Tian, H.; Chen, C. Aroma characteristics of traditional Huangjiu produced around Winter Solstice revealed by sensory evaluation, gas chromatography–mass spectrometry and gas chromatography–ion mobility spectrometry. Food Res. Int. 2021, 145, 110421. [Google Scholar] [CrossRef]
- Sun, H.; Liu, S.; Mao, J.; Yu, Z.; Lin, Z.; Mao, J. New insights into the impacts of huangjiu compontents on intoxication. Food Chem. 2020, 317, 126420. [Google Scholar] [CrossRef]
- Deed, N.K.; van Vuuren, H.J.J.; Gardner, R.C. Effects of nitrogen catabolite repression and di-ammonium phosphate addition during wine fermentation by a commercial strain of S. cerevisiae. Appl. Microbiol. Biotechnol. 2011, 89, 1537–1549. [Google Scholar] [CrossRef]
- Peng, Q.; Meng, K.; Zheng, H.; Yu, H.; Zhang, Y.; Yang, X.; Lin, Z.; Xie, G. Metabolites comparison in post-fermentation stage of manual (mechanized) Chinese Huangjiu (yellow rice wine) based on GC–MS metabolomics. Food Chem. X 2022, 14, 100324. [Google Scholar] [CrossRef]
- Wang, J.; Wang, D.; Huang, M.; Sun, B.; Ren, F.; Wu, J.; Meng, N.; Zhang, J. Identification of nonvolatile chemical constituents in Chinese Huangjiu using widely targeted metabolomics. Food Res. Int. 2023, 172, 113226. [Google Scholar] [CrossRef] [PubMed]
- Li, Q.; Song, X.; Yrjälä, K.; Lv, J.; Li, Y.; Wu, J.; Qin, H. Biochar mitigates the effect of nitrogen deposition on soil bacterial community composition and enzyme activities in a Torreya grandis orchard. For. Ecol. Manag. 2020, 457, 117717. [Google Scholar] [CrossRef]
- Sun, X.-H.; Qi, X.; Han, Y.-D.; Guo, Z.-J.; Cui, C.-B.; Lin, C.-Q. Characteristics of changes in volatile organic compounds and microbial communities during the storage of pickles. Food Chem. 2023, 409, 135285. [Google Scholar] [CrossRef] [PubMed]
- Tian, M.; Ding, S.; Yang, L.; Pan, Y.; Suo, L.; Zhu, X.; Ren, D.; Yu, H. Weissella confusa M1 as an adjunct culture assists microbial succession and flavor formation in gray sufu. LWT 2023, 185, 115155. [Google Scholar] [CrossRef]
- Sun, H.; Liu, S.; Zhang, J.; Zhang, S.; Mao, J.; Xu, Y.; Zhou, J.; Mao, J. Safety evaluation and comparative genomics analysis of the industrial strain Aspergillus flavus SU-16 used for huangjiu brewing. Int. J. Food Microbiol. 2022, 380, 109859. [Google Scholar] [CrossRef]
- Zhao, Y.; Liu, S.; Han, X.; Zhou, Z.; Mao, J. Combined effects of fermentation temperature and Saccharomyces cerevisiae strains on free amino acids, flavor substances, and undesirable secondary metabolites in huangjiu fermentation. Food Microbiol. 2022, 108, 104091. [Google Scholar] [CrossRef] [PubMed]
- Xue, Y.; Chen, H.; Yang, J.R.; Liu, M.; Huang, B.; Yang, J. Distinct patterns and processes of abundant and rare eukaryotic plankton communities following a reservoir cyanobacterial bloom. ISME J. 2018, 12, 2263–2277. [Google Scholar] [CrossRef]
- Liu, C.; Li, C.; Jiang, Y.; Zeng, R.J.; Yao, M.; Li, X. A guide for comparing microbial co-occurrence networks. iMeta 2023, 2, e71. [Google Scholar] [CrossRef]
- Wang, J.; Pan, Z.; Yu, J.; Zhang, Z.; Li, Y.-Z. Global assembly of microbial communities. mSystems 2023, 8, e01289-22. [Google Scholar] [CrossRef]
- Zhou, J.; Ning, D. Stochastic Community Assembly: Does It Matter in Microbial Ecology? Microbiol. Mol. Biol. Rev. 2017, 81, 10–1128. [Google Scholar] [CrossRef] [PubMed]
- Louw, N.L.; Lele, K.; Ye, R.; Edwards, C.B.; Wolfe, B.E. Microbiome Assembly in Fermented Foods. Annu. Rev. Microbiol. 2023, 77, 381–402. [Google Scholar] [CrossRef] [PubMed]
- Chen, W.; Ren, K.; Isabwe, A.; Chen, H.; Liu, M.; Yang, J. Stochastic processes shape microeukaryotic community assembly in a subtropical river across wet and dry seasons. Microbiome 2019, 7, 138. [Google Scholar] [CrossRef]
- Fang, G.-Y.; Mu, X.-J.; Huang, B.-W.; Wu, G.-Z.; Jiang, Y.-J. Fungal biodiversity and interaction complexity were the important drivers of multifunctionality for flavor production in a spontaneously fermented vinegar. Innov. Food Sci. Emerg. Technol. 2023, 83, 103259. [Google Scholar] [CrossRef]
- de Vries, F.T.; Griffiths, R.I.; Bailey, M.; Craig, H.; Girlanda, M.; Gweon, H.S.; Hallin, S.; Kaisermann, A.; Keith, A.M.; Kretzschmar, M.; et al. Soil bacterial networks are less stable under drought than fungal networks. Nat. Commun. 2018, 9, 3033. [Google Scholar] [CrossRef] [PubMed]
- Chadaideh, K.S.; Carmody, R.N. Host-microbial interactions in the metabolism of different dietary fats. Cell Metab. 2021, 33, 857–872. [Google Scholar] [CrossRef]
- Zhao, W.; Qian, M.; Dong, H.; Liu, X.; Bai, W.; Liu, G.; Lv, X.-C. Effect of Hong Qu on the flavor and quality of Hakka yellow rice wine (Huangjiu) produced in Southern China. LWT 2022, 160, 113264. [Google Scholar] [CrossRef]
- Losada, M.M.; Hernández-Apaolaza, L.; Morata, A.; Revilla, E. Impact of the application of monosilicic acid to grapevine (Vitis vinifera L.) on the chemical composition of young red Mencia wines. Food Chem. 2022, 378, 132140. [Google Scholar] [CrossRef]
- Wang, Y.; Li, C.; Zhao, Y.; Li, L.; Yang, X.; Wu, Y.; Chen, S.; Cen, J.; Yang, S.; Yang, D. Novel insight into the formation mechanism of volatile flavor in Chinese fish sauce (Yu-lu) based on molecular sensory and metagenomics analyses. Food Chem. 2020, 323, 126839. [Google Scholar] [CrossRef]
- Liu, S.; Hu, J.; Xu, Y.; Xue, J.; Zhou, J.; Han, X.; Ji, Z.; Mao, J. Combined use of single molecule real-time DNA sequencing technology and culture-dependent methods to analyze the functional microorganisms in inoculated raw wheat Qu. Food Res. Int. 2020, 132, 109062. [Google Scholar] [CrossRef]
- Zheng, N.; Jiang, S.; He, Y.; Chen, Y.; Zhang, C.; Guo, X.; Ma, L.; Xiao, D. Production of low-alcohol Huangjiu with improved acidity and reduced levels of higher alcohols by fermentation with scarless ALD6 overexpression yeast. Food Chem. 2020, 321, 126691. [Google Scholar] [CrossRef] [PubMed]
- Wei, J.; Zhang, Y.; Zhang, X.; Guo, H.; Yuan, Y.; Yue, T. Multi-omics discovery of aroma-active compound formation by Pichia kluyveri during cider production. LWT 2022, 159, 113233. [Google Scholar] [CrossRef]
- Zeng, J.; Sheng, F.; Hu, X.; Huang, Z.; Tian, X.; Wu, Z. Nutrition promotion of brewer’s spent grain by symbiotic fermentation adding Bacillus velezensis and Levilactobacillus brevis. Food Biosci. 2022, 49, 101941. [Google Scholar] [CrossRef]
- Carlin, S.; Mattivi, F.; Durantini, V.; Dalledonne, S.; Arapitsas, P. Flint glass bottles cause white wine aroma identity degradation. Proc. Natl. Acad. Sci. USA 2022, 119, e2121940119. [Google Scholar] [CrossRef] [PubMed]

Disclaimer/Publisher’s Note: The statements, opinions and data contained in all publications are solely those of the individual author(s) and contributor(s) and not of MDPI and/or the editor(s). MDPI and/or the editor(s) disclaim responsibility for any injury to people or property resulting from any ideas, methods, instructions or products referred to in the content. |
© 2024 by the authors. Licensee MDPI, Basel, Switzerland. This article is an open access article distributed under the terms and conditions of the Creative Commons Attribution (CC BY) license (https://creativecommons.org/licenses/by/4.0/).
Share and Cite
Jiang, J.; Fang, G.; Wu, C.; Wang, P.; Zhang, Y.; Zhang, C.; Wu, F.; Shan, Z.; Liu, Q.; Liu, X. The Addition of Glutamine Enhances the Quality of Huangjiu by Modifying the Assembly and Metabolic Activities of Microorganisms during the Fermentation Process. Foods 2024, 13, 2833. https://doi.org/10.3390/foods13172833
Jiang J, Fang G, Wu C, Wang P, Zhang Y, Zhang C, Wu F, Shan Z, Liu Q, Liu X. The Addition of Glutamine Enhances the Quality of Huangjiu by Modifying the Assembly and Metabolic Activities of Microorganisms during the Fermentation Process. Foods. 2024; 13(17):2833. https://doi.org/10.3390/foods13172833
Chicago/Turabian StyleJiang, Jiajia, Guanyu Fang, Changling Wu, Peng Wang, Yongzhu Zhang, Cheng Zhang, Fenghua Wu, Zhichu Shan, Qingru Liu, and Xingquan Liu. 2024. "The Addition of Glutamine Enhances the Quality of Huangjiu by Modifying the Assembly and Metabolic Activities of Microorganisms during the Fermentation Process" Foods 13, no. 17: 2833. https://doi.org/10.3390/foods13172833
APA StyleJiang, J., Fang, G., Wu, C., Wang, P., Zhang, Y., Zhang, C., Wu, F., Shan, Z., Liu, Q., & Liu, X. (2024). The Addition of Glutamine Enhances the Quality of Huangjiu by Modifying the Assembly and Metabolic Activities of Microorganisms during the Fermentation Process. Foods, 13(17), 2833. https://doi.org/10.3390/foods13172833





